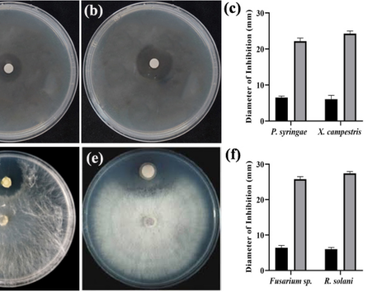
Isolation and characterization of Bacillus subtilis RZS-01 isolate from agricultural soil in Bangladesh with potent antimicrobial activities

Vol 38 Issue 3, June 2025
Total Articles: 46

Impact of elevated CO2 on yield, nutritional and medicinal properties of Corchorus olitorius
Research Articles
Views: 2025
Pages: 1029-1038
Published: 24 June, 2024
Doi: 10.1007/s42535-024-00910-7

Induced resistance to mitigate phomopsis blight of brinjal using inorganic chemicals
Research Articles
Views: 3536
Pages: 1039-1046
Published: 22 April, 2024
Doi: 10.1007/s42535-024-00889-1

Influence of culture media and growth hormones on in vitro propagation of Adinandra griffithii Dyer., a critically endangered and endemic plant from northeast India
Research Articles
Views: 2814
Pages: 1047-1054
Published: 23 April, 2024
Doi: 10.1007/s42535-024-00900-9

Competition between alien and native species in xerothermic steno-Mediterranean grasslands: Cenchrus setaceus and Hyparrhenia hirta in Sicily and southern Italy
Research Articles
Views: 2796
Pages: 1055-1062
Published: 23 April, 2024
Doi: 10.1007/s42535-024-00871-x

Phytochemical, enzymatic antioxidant, and nonenzymatic antioxidant metabolism during germination of Cajanus scarabaeoides seeds
Research Articles
Views: 3063
Pages: 1063-1071
Published: 25 April, 2024
Doi: 10.1007/s42535-024-00876-6

Plant architecture manipulation and growth retardants influencing the Pot presentability of China aster (Callistephus chinensis L. Nees)
Research Articles
Views: 2583
Pages: 1072-1079
Published: 25 April, 2024
Doi: 10.1007/s42535-024-00890-8

Two new records of Henckelia for India from Arunachal Pradesh
Research Articles
Views: 2604
Pages: 1080-1084
Published: 29 April, 2024
Doi: 10.1007/s42535-024-00905-4
Isolation and characterization of Bacillus subtilis RZS-01 isolate from agricultural soil in Bangladesh with potent antimicrobial activities
Research Articles
Views: 2567
Pages: 1085-1092
Published: 01 May, 2024
Doi: 10.1007/s42535-024-00882-8

Vitamins enhance the physiological characteristics of coffee cultivated in the Brazilian Cerrado
Research Articles
Views: 1876
Pages: 1093-1099
Published: 21 September, 2024
Doi: 10.1007/s42535-024-01033-9